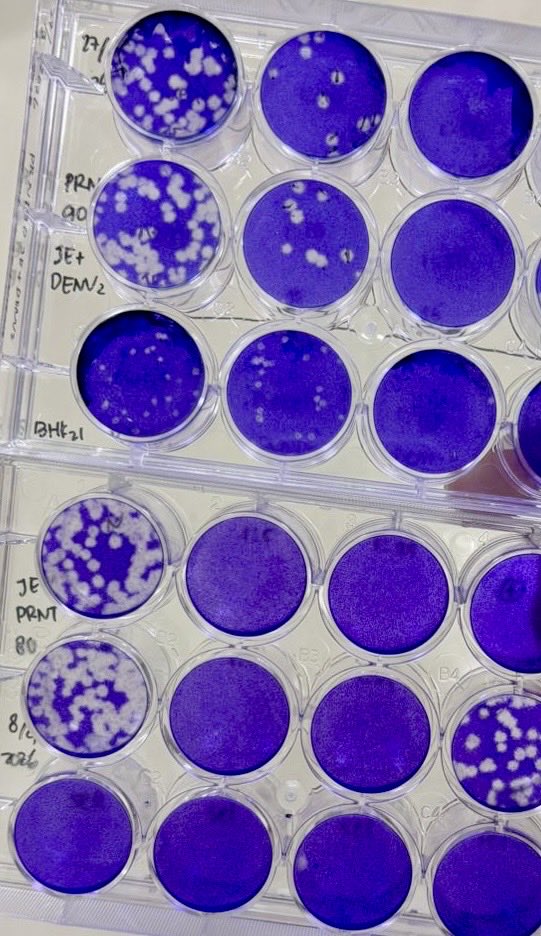
Yora | ᬬᭀᬭ | ꦪꦺꦴꦫ tweet media

Sabitlenmiş Tweet
Yora | ᬬᭀᬭ | ꦪꦺꦴꦫ
24.9K posts


Yora | ᬬᭀᬭ | ꦪꦺꦴꦫ
@yrprmtdw
Research Scientist | Biomedical Science | Emerging Pathogens | Arboviruses & Zoonoses | Bridging research & public health |
Emerging Virus Research Group Katılım Temmuz 2009
342 Takip Edilen345 Takipçiler

After a long wait, it is incredibly rewarding to finally see this study published.
🔗 doi.org/10.1016/j.jiph…
In this study, we investigated the 2021–2022 #chikungunya #outbreak in Bali, where more than 900 suspected cases were reported.
English

I’ve officially started Week 1 of 6 of the Biology of Vector-Borne Diseases Online Course at the University of Idaho after being awarded a full scholarship (USD 1,500), funded by the U.S. National Science Foundation’s Ecology and Evolution of Infectious Diseases Program.
@ui_IHHE

English

The world of work is changing fast—we need to keep learning and adapting.
Excited to #TakeAStepForward with the McKinsey.org Forward program, a 10-week virtual learning experience 🚀
mckinsey.org/forward @McKinsey


English

I’m excited to share that our research article has just been published in @PLOSONE!
doi.org/10.1371/journa…
English

@astriferdiana @AmirahWahdi @DitjenPajakRI @Kemdiktisaintek Betul. Beberapa hari lalu ngurusin ini juga. Publisher untungnya provides certificate kalau mereka non-profit dan free from service tax atau tax deduction. Tho masih perlu submit form DGT yang publisher lengkapi
Indonesia

@AmirahWahdi @DitjenPajakRI @Kemdiktisaintek Iya dan tergantung tax treaty antar negara gmn. Ini salah satu pusat studi ada yg udh kena pajak 2 jurnal.
Indonesia

Hai @DitjenPajakRI, tau g susahnya ngumpulin dana buat bayar APC? Kalau negara g bisa bayar biaya publikasi ilmiah penelitinya, minimal jgn nambah beban. @Kemdiktisaintek diam aja nih? Mana Wamen kalian yg heboh ttg go internasional? Udh tau blm ttg ini?
Astri Ferdiana@astriferdiana
Ga masuk akal banget, bayar article processing charges ke jurnal internasional skrg dikenakan pajak 12%. Dikira ini barang mewah? pajak.go.id/id/digitaltax Di sini ada list penerbit2 yang transaksinya kena pajak: Elsevier, Cambridge, Springer dsb.
Indonesia
Yora | ᬬᭀᬭ | ꦪꦺꦴꦫ retweetledi

The #ImmunoCambodia2025 Participant Report is out!
Grateful to have been part of this amazing course in Nov 2025🧬🦠🦟🇰🇭
Thanks @Immunopaedia
🔗 immunopaedia.org.za/online-courses…
English
Yora | ᬬᭀᬭ | ꦪꦺꦴꦫ retweetledi